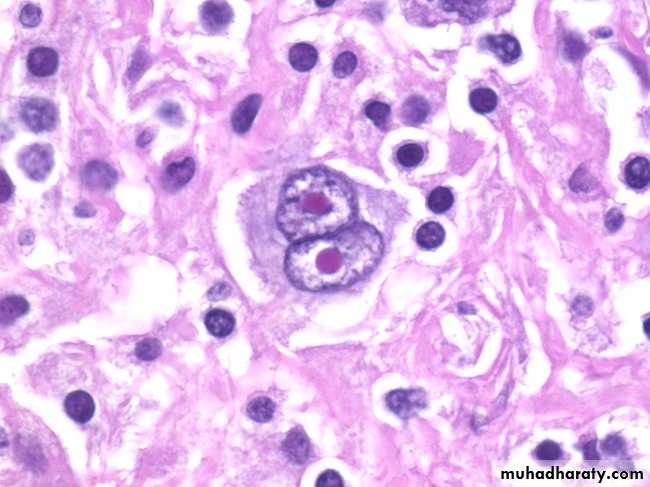
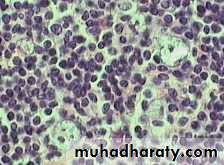
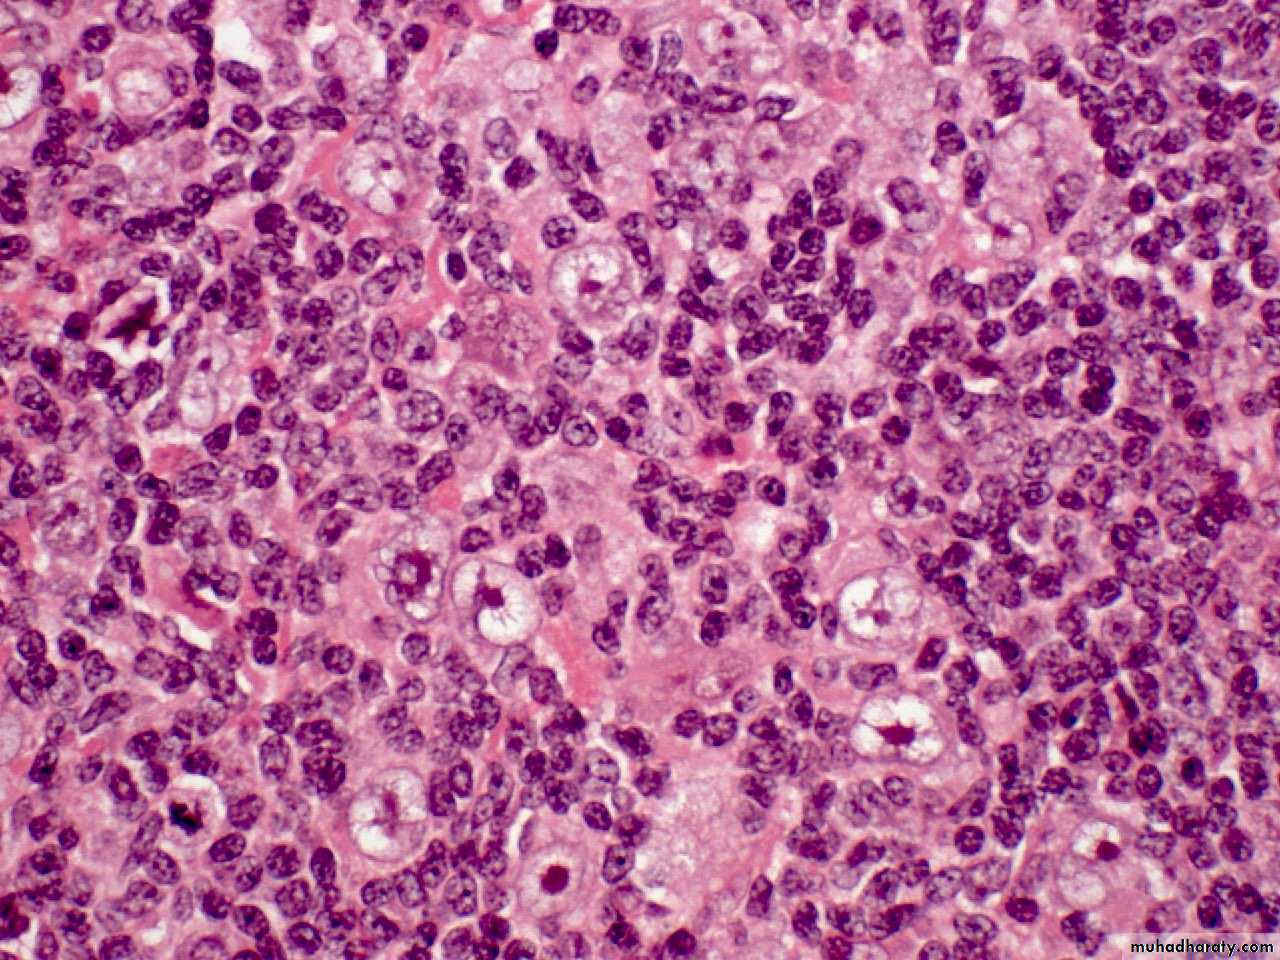
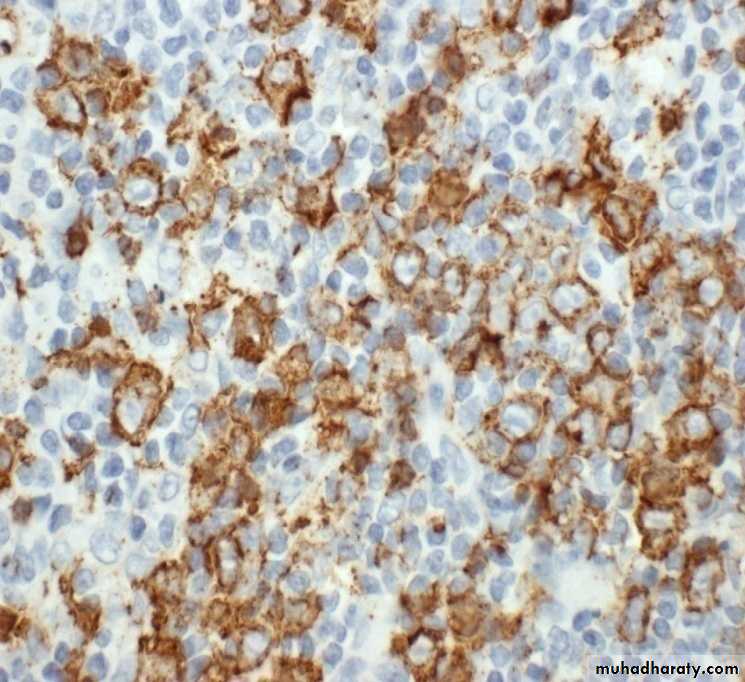

Reactive hyperplasias
Exaggerations of normal histology.Expansion of all regions or selective expansion
Some types characteristic of certain diseases, but most not
Follicular hyperplasia- increase in number and size of germinal centers, spread into paracortex, medullary areas
Collagen vascular diseases
Systemic toxoplasmosis
Syphillis
Interfollicular hyperplasia- paracortex
Skin diseases
Viral infections
Drug reactions
Sinus histiocytosis- expansion of the medullary sinus histiocytes-
Adjacent cancer
Infections
F. 63 ISOLATED ENLARGED LT. SUBMANDEBULAR LYMPH NODE
Follicular hyperplasia lymph node LP mic
There is marked differences in size of germinal centers, their well-circumscribed character, and the fact that they are surrounded by a well-defined mantle of lymphocytes
Lymphoma
Clonal malignant disorders that are derived from lymphoid cells: either precursor or mature T-cell or B-cellMajority are of B- cell origin
Divided into 2 main types :1. Hodgkin’s lymphoma
2. Non - Hodgkin’s lymphoma
Etiology
? Infection – EBV? Environmental factors
REAL* ClassificationClassic:
Nodular Sclerosis
Lymhocyte rich
Mixed Cellularity
Lymhocyte depleted
Non-Classic
Nodular Lymphocyte predominant*REAL – Revised European,American,lymphoma
Hodgkin Lymphoma
Nodular lymphocyte-predominant Hodgkin lymphomaClassical Hodgkin lymphoma
Nodular sclerosis classical Hodgkin lymphoma
Lymphocyte-rich classical Hodgkin lymphoma
Mixed cellularity classical Hodgkin lymphoma
Lymphocyte-depleted classical Hodgkin lymphoma
The etiology of Hodgkin's lymphoma remains
unknown, but there is considerable evidence to suggestthat the EBV plays an important role
Clinical features
Bimodal age distribution :young adults ( 20-30 yrs) & elderly (> 50yrs) May occur at any age
M > F
Lymphadenopathy:
most often cervical region
asymmetrical, discrete
painless, non-tender
elastic character on palpation ( rubbery)
not adherent to skin
fluctuate in size
Constitutional symptoms ( B symptoms )
Night sweats,
sustained fever > 38 degree celsius,
loss of weight >10% of body weight in 6 mo
Fever sometimes cyclical (‘Pel-Ebstein fever’)
Pain at the site of disease after drinking alcohol
Pallor
Pruritis
Symptoms of Bulky (>10 cm) disease
Gross features
lymph nodes involved by Hodgkin's lymphoma are enlarged, sometimes massivelyso. The gross appearance depend on the microscopic subtypes The consistency
varies from soft to hard depending on the amount of fibrosis
. Some degree of nodularity is often appreciated, particularly in the nodular sclerosis
Foci of necrosis may be present the cut surface of the node has a more heterogeneous
appearance than most non-Hodgkin's lymphoma. in advanced cases, several nodes from the same group
become matted together
CHD
Reed-Sternberg cell
The classic Reed-Sternberg cell, as seen in all subtypes of
classical Hodgkin's lymphoma, but not in NLPHL,
most important immunocytochemical profile of the Reed-
Sternberg cell is. CD15 (Leu-Ml): This is expressed in over 80% of the
cases; the pattern may be paranuclear (corresponding
to the Golgi region), diffuse cytoplasmic, and/or corresponding
to the cell membrane.
. CD30 (Ki-1): As recqgnized by the monoclonal antibody
Be-Hz, this is found in approximately 90% of the
cases, .
. CD45 (1CA): This is expressed in less than 10% of the
cases.
. .
. CD40 (a protein present in B cells and nerve growth
factor receptor): This is expressed in approximately 70%.
. CD74: This is e~pressed i~ over 75%.
Hodgkin's Histologic subtypes
Are characteristic patterns of involvement, and characteristic variants of Reed Sternberg cell associated with different subtypes
Nodular sclerosing HL
Most common type Hodgkin's lymphoma in US/Europe
Usually presents in the anterior mediastinum and neck of young adult females
Characterized by fibrotic capsule and bands subdividing tissue and
Lacunar variant Reed Sternberg cell
Histologic subtypes 2
Lymphocyte predominantUsually presents with limited disease in the neck of young adults
Associated with L and H (lymphocytic and histiocytic) or "popcorn cell" variant RS cell
Mixed cellularity
More extensive disease
Older patients than NS and LP
More R-S cells, eosinophils, plasma cells
Mononuclear variant R-S cells
Inherently more aggressive disease
Lymphocyte depleted
Often presents in retroperitoneum, older patients
Accompanied by loss lymphocytes, sclerosis and pleomorphic RS cell variants
Also more aggressive disease
General and clinical features
Hodgkin's lymphoma comprises approximately 20% to30% of all malignant lymphomas in the United Statesand Western Europe but a much lower percentage inJapan and other Oriental countries.with a peak at 15 to 40 years and a second,
smaller peak in the seventh decade
In poorly developed countries,
there is a high incidence in children, a relatively low
incidence in the 15- to 40-year age group,
The is a male predominent (approximately 1.5 to 1) in all microscopic types except nodular sclerosis
. The disease may present in a variety of ways
the most common (approximately 90% of the cases) being painless enlargement of superficial (usually cervical) lymph node
Fever, night sweats, and loss of weight (so-called "B symptoms") occur in approximately 25% of the cases; their presence influences the clinical staging
Pruritus is also frequent.
Patterns of spreadHodgkin's lymphoma spreads contiguously via lymphatics
Staging as in NHL- may or may not include laparotomy/splenectomy
Prognosis
Hodgkin's lymphoma is a curable malignancyOverall cure rate approximately 80%
With modern therapy, prognosis based more on staging, bulk of disease, than morphologic subtype
M. 63Y. PELVIC AND GROIN LYMPHADENOPATHY
M.57Y. ISOLATED CERVICAL LYMPHADENOPATHY
M.57Y. ISOLATED CERVICAL LYMPHADENOPATHY
F. 41Y.CERVICAL LYMPHADEOPATHY AND SPLEENOMEGALY
PB 14783 – 05 M.78Y. WEIGHT LOSS, DIARRHOEA, LT. GRIN LYMPHADENOPATHY
LCA
CD15
CD30
CD3
CD20
M. 39Y. PARA AORTIC, MESENTRIC LYMPHADEOPATHY,ANAEMIA,LETHARGY, NODE BIOPSY
M. 39Y. PARA AORTIC, MESENTRIC LYMPHADEOPATHY,ANAEMIA,LETHARGY, NODE BIOPSY
NSCHD
M. 39Y. PARA AORTIC, MESENTRIC LYMPHADEOPATHY,ANAEMIA,LETHARGY, NODE BIOPSYHodgkin's disease, nodular sclerosis type, lacunar cell HP mic
large cells with a surrounding prominent clear space, an artefact of formalin fixation. These are the lacunar cells characteristic for the nodular sclerosis type of Hodgkin's disease.M. 39Y. PARA AORTIC, MESENTRIC LYMPHADEOPATHY,ANAEMIA,LETHARGY, NODE BIOPSY
CD45
CD20CD15
CD30EBV
CD3